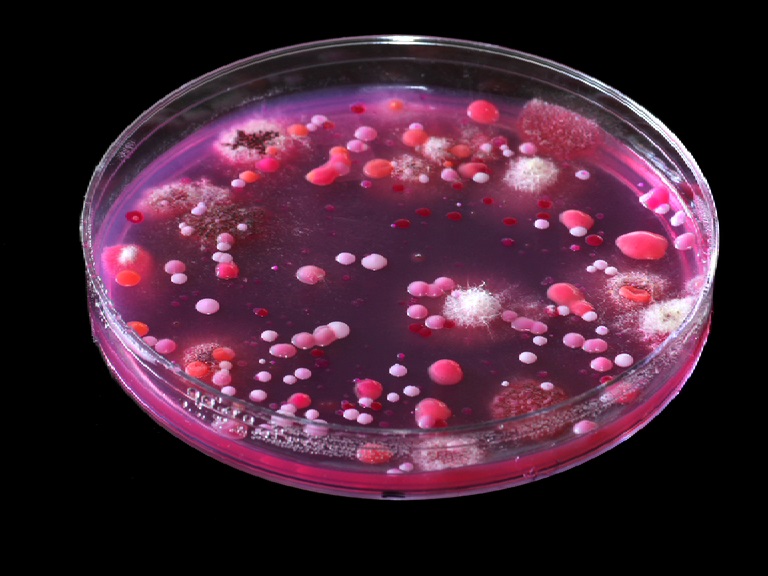

A great number of infections can live in the human body without showing any symptom and cause sudden death. There are many diseases that do not show any symptoms, and they can kill you in just a few hours.
Here’s a list of the 7 most dangerous diseases in the world:
1. Necrotizing Fasciitis
It’s a bacterial infection that spreads really fast and destroys the soft tissue. It can appear after food poisoning, having a surgery, delivery, chronic diseases, etc. This infection is also called acute skin gangrene and the first symptoms are similar to flu symptoms. The infected person starts getting dark spots on the skin and as the disease spreads, the human flesh turns black and dies. It’s extremely important to get medical help, to remove the infected tissue and get antibiotics.
2. Cerebrovascular Diseases
It’s a damage of one or more blood vessels in the brain. When the blood supply to part of the brain is blocked or interrupted that causes a stroke. A stroke is the most common cerebrovascular diseases and it can cause a part of the brain to die or death.
3. MRSA- Methicillin-Resistant Staphylococcus Aureus
This is a bacteria that’s resistant to antibiotics and it’s transferred by touch. It causes dangerous blood infections and lung inflammation. Some of the symptoms include high body temperature, fever, muscle pain; red, swollen, painful spots on the skin. The infection can cause sepsis, heart infection, bones infection and lung inflammation.
4. Cholera
Cholera is an acute intestinal infection caused by drinking water or eating foods that contain the bacteria Vibrio cholerae. In extreme cases, cholera can kill a man in just a few hours. The incubation period is short- from a few hours to 5 days. The person infected has severe diarrhea that leads to severe dehydration and death, if not treated in time.
5. Bubonic Plague
It’s the most famous plague, also known as “the Black Death”, that has killed more than 50 million people. It’s caused by the bacteria Yersinia pestis and it incubation lasts from a couple of hours up to 12 days. Some of the symptoms are really high body temperature and swollen glands under the armpits. If the disease is not treated in time, it can cause death in 2-5 days.
6. Ebola
This is an extremely dangerous disease that causes death in 90% of people infected. The disease transfers through blood and bodily fluids. Incubation lasts between 2 days and 3 weeks and the symptoms include a sudden fever, weakness, muscle pain, headaches, throat pain, throwing up, diarrhea, rashes, kidney damage, liver damage, internal and external bleeding. Death can occur in just 24 hours.
7. Dengue Fever
This tropical disease is transferred through mosquitoes infected by the virus dengue. The symptoms include high body temperature, headache, muscle pain, joint pain and rashes that look like chickenpox.